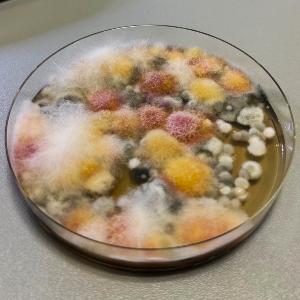

Ausbildung Biologielaborant / Biologielaborantin
Eine Ausbildung voller Vielfalt – lerne bei uns alles vom Ansetzen einer Kultur bis zum Forschungsergebnis.

Eine Ausbildung voller Vielfalt – lerne bei uns alles vom Ansetzen einer Kultur bis zum Forschungsergebnis.
In der dreieinhalbjährigen dualen Ausbildung zum Biologielaboranten / zur Biologielaborantin sammelst du sowohl in unseren Laboren als auch in der Berufsschule vielfältige praktische und theoretische Erfahrungen.
Am Lehrstuhl unterstützt du die wissenschaftliche Forschung im Bereich der Lebensmittelsicherheit, analysierst Proben, wertest die Ergebnisse sorgfältig aus und dokumentierst sie.
Während verschiedener Praktika an anderen Einrichtungen des öffentlichen Dienstes lernst du zudem den Umgang mit Versuchstieren – insbesondere mit Mäusen – kennen. Du beobachtest ihr Verhalten, entnimmst Proben und erwirbst Kenntnisse in artgerechter Haltung.
Der Berufsschulunterricht ergänzt die praktischen Erfahrungen mit fundiertem Wissen in den Bereichen Biologie und Chemie, aber auch hinsichtlich Fachenglisch, sowie Politik und Gesellschaft.
👉 Weitere Informationen findest du auf der Website der zuständigen Berufsschule: https://bs-zt-chem.musin.de/

Am 1. September startest du in die Ausbildung und wirst bei uns am Lehrstuhl willkommen geheißen. In einer Einführungswoche lernst du gemeinsam mit anderen Auszubildenden die Grundlagen der Laborarbeit kennen. Im Verlauf der Ausbildung wechseln sich praktische Tätigkeiten im Labor und Praktika an anderen Einrichtungen mit dem zweiwöchigen Blockunterricht an der Berufsschule ab.
Die Abschlussprüfung besteht aus zwei Teilen, die von der IHK München und Oberbayern abgenommen werden:
Beide Prüfungen beinhalten jeweils einen theoretischen und einen praktischen Teil.
Nach bestandener Prüfung bist du anerkannter Biologielaborant / anerkannte Biologielaborantin – und damit bestens qualifiziert für Tätigkeiten in Industrie und Forschung.

Wenn du sorgfältig, genau und verantwortungsbewusst arbeitest, gerne praktisch tätig bist und dich für Forschung und Wissenschaft begeisterst, bist du bei uns genau richtig.
Wenn du dagegen lieber im Büro arbeitest, dich beim Umgang mit chemischen Stoffen unwohl fühlst oder nicht mit Tierversuchen arbeiten möchtest, ist ein anderer Beruf vermutlich besser für dich geeignet.
Deine Vergütung richtet sich nach TVA-L BBiG (ab 01.02.2025, Bruttobeträge):
Melde dich bei Fragen gerne bei uns unter ausbildung@ls.vetmed.uni-muenchen.de.

Technische Assistentin
Ausbilderin Biologielaborant:innen

Technische Assistentin
Ausbilderin Biologielaborant:innen, Prüferin (IHK)